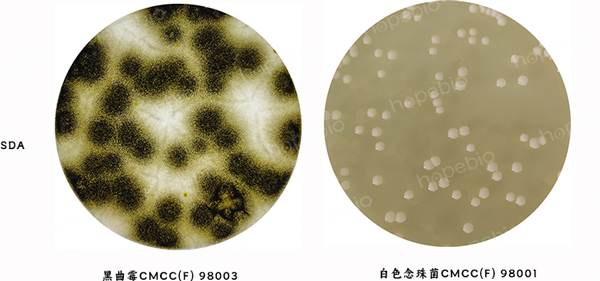

用途:用于真菌检测。
成分(g/L)
蛋白胨
|
10.0
|
葡萄糖
|
40.0
|
pH值5.6±0.2
|
25℃
|
检验原理:
蛋白胨提供微生物生长所需的碳源、氮源、维生素和生长因子;葡萄糖为可发酵糖类。
用法:
称取本品50.0g,加热溶解于1000ml蒸馏水中,分装,115℃高压灭菌15分钟,备用。
沙堡弱液体培养基微生物质控结果:

培养基来源:


沙堡弱液体培养基微生物灵敏度试验:
按标签用法制备培养基,接种以下质控菌株,放置20-25℃需氧培养48-72小时。

相关资料:
沙堡弱液体培养基检验原理和使用方法 点击查看
GB 15979-2024 一次性使用卫生用品卫生要求 点击查看


 海博微信公众号
海博微信公众号
 海博天猫旗舰店
海博天猫旗舰店


 海博微信公众号
海博微信公众号
 海博天猫旗舰店
海博天猫旗舰店






